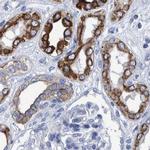
MKS1 Antibody in Immunohistochemistry (IHC)

Search
Invitrogen
MKS1 Polyclonal Antibody
{{$productOrderCtrl.translations['antibody.pdp.commerceCard.promotion.promotions']}}
{{$productOrderCtrl.translations['antibody.pdp.commerceCard.promotion.viewpromo']}}
{{$productOrderCtrl.translations['antibody.pdp.commerceCard.promotion.promocode']}}: {{promo.promoCode}} {{promo.promoTitle}} {{promo.promoDescription}}. {{$productOrderCtrl.translations['antibody.pdp.commerceCard.promotion.learnmore']}}
产品信息
PA5-54515
种属反应
宿主/亚型
分类
类型
抗原
偶联物
形式
浓度
规格
纯化类型
保存液
内含物
保存条件
运输条件
RRID
产品详细信息
Immunogen sequence: TCTTKSLAMD KVAHFSYPFT FEAFFLHEDE SSDALPEWPV LYCEVLSLDF WQRYRVEGYG AVVLPATPGS HTLTVSTWRP VELGTVA
Highest antigen sequence identity to the following orthologs: Mouse - 87%, Rat - 85%.
靶标信息
The protein encoded by this gene localizes to the basal body and is required for formation of the primary cilium in ciliated epithelial cells. Mutations in this gene result in Meckel syndrome type 1 and in Bardet-Biedl syndrome type 13. Multiple transcript variants encoding different isoforms have been found for this gene.
仅用于科研。不用于诊断过程。未经明确授权不得转售。
篇参考文献 (0)
生物信息学
蛋白别名: FLJ20345; Meckel syndrome type 1 protein; POC12 centriolar protein homolog; Tectonic-like complex member MKS1; unnamed protein product
基因别名: BBS13; JBTS28; MES; MKS; MKS1; POC12
UniProt ID: (Human) Q9NXB0
Entrez Gene ID: (Human) 54903